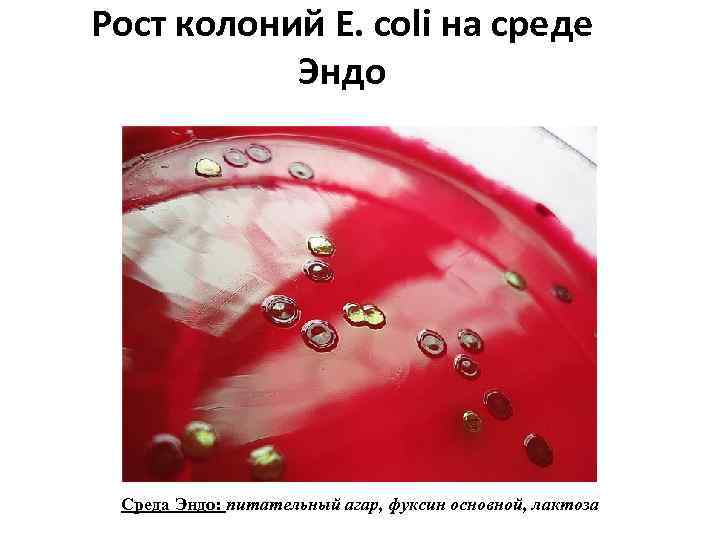

79adc5db_zan_n_2_enerobakterii_2015 (1).ppt
- Количество слайдов: 39

Лабораторная диагностика заболеваний, вызываемых энтеробактериями

Семейство Enterobacteriaceae 30 родов Escherichia Salmonella Shigella Klebsiella Yersinia

Салмон Дэниел Элмер (1850 -1914) ШИГА (Сига) Киёси (1871 -1957) Э шерих (Escherich) Теодор (1857— 1911) Александр Иерсен (1863 -1943) Эдвин Клебс (1834 -1913)

Escherichia coli

Мазок из чистой культуры E. coli Окраска по Граму
Рост колоний E. coli на среде Эндо Среда Эндо: питательный агар, фуксин основной, лактоза

Факторы патогенности кишечной палочки Адгезины Фимбрии Белки наружной мембраны Бактериальные липосахариды Факторы инвазии Белки наружной мембраны Эндотоксины Экзотоксины 1. Цитотонины • Термолабильный энтеротоксин (субъединицы А 1, А 2 и В) • Термостабильный энтеротоксин 2 типов 2. Цитотоксины (шигаподобные)

Веротоксины (шигаподобные токсины) веротоксины 1 (VT 1, SLT 1, Stx 1) веротоксины 2 (VT 2, SLT 2, Stx 2)

• Имеют факторы адгезии, колонизации, энтеротоксины. Энтеротоксигенные • Холероподобная кишечные палочки диарея. • ETEC

• Имеют факторы адгезии, колонизации, цитотоксин. Энтеропатогенные • Поражают тонкий кишечные палочки кишечник с образованием воспаления и эрозий. • EPEC

• EIEC Энтероинвазивные кишечные палочки • Разрушают энтероциты подвздошной и толстой кишки. • Заболевание по типу дизентерии.

• EHEC Энтерогеморрагические кишечные палочки Фактор адгезии – белок интимин, веротоксины (шигаподобные), энтерогемолизин. • Вызывают геморрагический колит, гемолитикоуремический синдром

• EAEC Энтероадгезивные кишечные палочки • Быстро прикрепляются к поверхности клеток. • Цитотоксины не образуют.

Классификация диареегенных Еscherichia coli Категория Серогруппы Сероварианты ETEC O 6, О 8, О 15, О 20, О 25, О 27, О 63, О 78, О 80, О 85, О 115, О 128 ас, О 139, О 148, О 153, О 159, О 167. О 6: Н 16, О 8: Н 9, О 15: Н 11, О 128: Н 7, О 148: Н 28, О 149: Н 10, О 159: Н 20 И ДР. EIEC О 28 ас, О 29, О 124, О 136, О 28 ас: Н-, О 124: Н 32, О 143, О 144, О 152, О 164, О 167. О 159: Н 2, О 167: Н 4, О 55, О 86, О 111, О 119, О 125, О 167: Н 5, О 124: Н 30 И ДР. О 126, О 127. EPEC О 128 ав, О 142. О 18, О 44, О 112, О 114. EHEC О 157, О 26, О 111, О 103, О 145. О 157: Н 7. EAEC О 18 ас: Н 7, О 20 ав: Н 26, О 26: Н-, О 55: Н 6, О 55: Н 7, О 114: Н 10 И ДР. Не выяснены.

Классификация сальмонелл Семейство Род Вид Подвиды Enterobacteriaceae Salmonella S. enteritica S. choleraesuis S. salamae S. arizonae S. diarizonae S. houtenae S. indica S. bongori S. typhi, S. enteritidis Серотипы (>2500)

Факторы патогенности сальмонелл - Устойчивость к действию желудочного сока - Адгезия к эпителию кишечника, пейеровым бляшкам и солитарным фолликулам; колонизация - Инвазия в энтероциты, бокаловидные клетки, макрофаги)

- Ускоренное размножение вне ЖКТ (кодируется плазмидой вирулентности) - Резистентность к бактерицидному действию сыворотки крови - Эндотоксин - Экзотоксины (энтеротоксины, шигаподобные цитотоксины)

Классификация шигелл Семейство Enterobacteriaceae Род Shigella Подгруппа А не ферментирует маннит Подгруппа В обычно ферментирует маннит Sh. dysenteriae 1 -12 серотипы Sh. flexneri 1 -6 серотипы, вариант Х, вариант Y (подсеротипы: 1 a, 2 b, 2 a, 2 b, 3 a, 3 b, 3 c, 4 a, 4 b)

Подгруппа С обычно ферментирует маннит Подгруппа D обычно ферментирует маннит, поздно лактозу и сахарозу Sh. boydii 1 -18 серотипы Sh. sonnei

Мазок из чистой культуры S. flexneri Окраска по Граму

Антигены бактериальной клетки Н-антиген A-антиген L-антиген B-антиген О-антиген Vi-антиген

Факторы патогенности шигелл Факторы адгезии и колонизации • Пили • Белки наружной мембраны • ЛПС клеточной стенки • Ферменты агрессии Экзотоксины Защита от факторов иммунитета 1. Защита от фагоцитоза • микрокапсула • ЛПС клеточной стенки 2. Подавление иммунной памяти • Липид А эндотоксина Токсины Эндотоксин Шига шигаподобные термолабильные энтеротоксины нейротоксины 1 -2 стимулируют активность цитотоксин аденилатциклазы

Биохимические свойства индол сахароза мальтоза маннит глюкоза лактоза H 2 S E. coli кг кг - + - S. enterinidis - кг кг кг - - + S. paratyphi A - кг кг кг - - - S. paratyphi B - кг кг кг - - + S. typhi - к к к - - + S. dysenteriae - к - - - S. flexneri - к к к - + - S. boydii - к к к - + - S. sonnei к к к - - 3 сут

ПРИНЦИП БАКТЕРИОЛОГИЧЕСКОЙ ДИАГНОСТИКИ ИНФЕКЦИЙ, ВЫЗЫВАЕМЫХ ЭНТЕРОБАКТЕРИЯМИ Выделение чистой культуры Посев исследуемого материала на среды Эндо, Плоскирева, Левина, желчный бульон Идентификация выделенной чистой культуры семейство Морфология (Грам- палочки) Культуральные свойства род Биохимические свойства (среды Гисса) вид, серогруппа, серотип Реакция агглютинации с поливалентными и монорецепторными сыворотками

Протокол. Лабораторная диагностика кишечных инфекций, вызываемых энтеробактриями Исследуемый материал Что сделать Мазок-препарат из Изучить культуры E. coli, морфологию, окраска по Граму зарисовать Результат Рисунок Мазок-препарат из культуры S. enteritidis, окраска по Граму Изучить морфологию, зарисовать Рисунок Мазок-препарат из культуры S. sonnei, окраска по Граму Изучить морфологию, зарисовать Рисунок

День иссле дова ния Исследуемый материал Рост колоний на среде Эндо Что сделать Описать морфологию колоний (демонстрация) 1 Салат (№ 1) день Испражнения (№ 2) Произвести посев материала на чашку со средой Плоскирева (Среда Плоскирева: питательный агар, натриевые соли желчных кислот, лактоза, бриллиантовый зеленый, нейтральный красный, йод, сода кальцинированная) Результат Описание

2 день Рост колоний на среде Плоскирева 1. Описать морфологию колоний 2. Приготовить мазок-препарат, окрасить методом Грама, микроскопировать, зарисовать 3. Изучить антигенные свойства материала из колоний в РА на стекле с поливалентной сальмонеллезной сывороткой групп А, B, C, D, E (пробирка № 1) 4. Пересев материала из агглютинирующейся колонии на скошенный агар с целью накопления чистой культуры Описание Рисунок, заключение

Реакция агглютинации на стекле


3 день 4 день Рост культуры на скошенном агаре Рост культуры на средах пестрого ряда 1. Оценить чистоту накопленной культуры (описать характер роста, приготовить мазок, окрасить методом Грама) 2. Посев на среды пестрого ряда для определения биохимических свойств 3. Изучить антигенные свойства в РА на стекле с адсорбированными сальмонеллезными монорецепторными сыворотками: О-4 (пробирка № 2), О-9 (пробирка № 3), H-m (пробирка № 4), H-i (пробирка № 5) Изучить биохимические свойства Рисунок, заключение

СЕРОЛОГИЧЕСКАЯ КЛАССИФИКАЦИЯ САЛЬМОНЕЛЛ Кауфмана-Уайта cерогруппа А Н-антиген серотип О-антиген 1 фаза 2 фаза D E a - 1, 4(5), 12 b 1, 2 S. typhimurium 1, 4(5), 12 i 1, 2 S. haifa C 1, 2, 12 S. paratyphi B B S. paratyphi A 1, 4(5), 12 z 1, 2 6, 7 c 1, 5 S. typhi 9, Vi, 12 d - S. enteritidis 1, 9, 12 g, m - 3, 10 c, h 1, 6 S. choleraesuis S. anatum

Серологическая диагностика кишечных инфекций Сыворотка РНГА крови больного (демонстрация) с подозрением на дизентерию Рисунок, заключение

Реакция непрямой гемагглютинации.

Схема РНГА для диагностики дизентерии 1: 200 1: 400 1: 800 1: 1600 1: 3200 1: 6400 Сыворотка больного, мл 0, 25 0, 25 Эритроцитарный диагностикум шигелл Флекснера, мл 0, 25 0, 25 Эритроцитарный диагностикум шигелл Зонне, мл 0, 25 0, 25 Физ. Контроль гемагглютинации 1: 100 Контроль эритроцитарного диагностикума Разведения сывороток 0, 25 Контр. + сыв-ка 0, 25 мл 0, 25 0, 25

УЧЕТ РНГА Разведения сыворотки 1: 100 1: 200 1: 400 1: 800 1: 1600 Эритроцитарный диагностикум шигелл Флекснера, мл Эритроцитарный диагностикум шигелл Зонне, мл Диагностический титр – 1: 200 1: 3200 1: 6400 КЭД КГА

ВАКЦИНА БРЮШНОТИФОЗНАЯ Ви - ПОЛИСАХАРИДНАЯ ЖИДКАЯ (ВИАНВАК ®) РРаствор капсульного полисахарида, извлеченного из супернатанта культуры Salmonella typhi, очищенного ферментативными и физико химическими методами; консервант — фенол. Бесцветная прозрачная жидкость. НАЗНАЧЕНИЕ Профилактика брюшного тифа у взрослых и детей в возрасте от 3 лет.

Первоочередной вакцинации подлежат: • население, проживающее на территориях с высоким уровнем заболеваемости брюшным тифом; • население, проживающее на территориях при хронических водных эпидемиях брюшного тифа; • лица, занятые в сфере коммунального благоустройства (работники, обслуживающие канализационные сети, сооружения и оборудование, а также предприятий по санитарной очистке населенных мест - сбор, транспортировка и утилизация бытовых отходов); • лица, работающие с живыми культурами возбудителей брюшного тифа; • лица, отъезжающие в гиперэндемичные по брюшному тифу регионы и страны, а также контактным в очагах по эпидпоказаниям. • По эпидемическим показаниям прививки проводят при угрозе возникновения эпиде мии или вспышки (стихийные бедствия, крупные аварии на водопроводной и канализационной сети), а также в период эпидемии, при этом в угрожаемом районе проводят массовую иммунизацию населения. Способ применения и дозировка • Прививки производят однократно. • Вакцину вводят подкожно в наружную поверхность верхней трети плеча. Прививочная доза составляет 0, 5 мл (25 мкг). • Ревакцинации проводятся по показаниям через каждые 3 года

Вакцина дизентерийная против ШИГЕЛЛ ЗОННЕ липосахаридная жидкая ШИГЕЛЛВАК ® • Вакцина дизентерийная против шигелл Зонне липополисахаридная жидкая - раствор липополисахарида, извлеченного из культуры Shigella sonnei, очищенного ферментативными и физико - химическими методами. Консервант - фенол. Бесцветная прозрачная жидкость. ИММУНОЛОГИЧЕСКИЕ СВОЙСТВА • Введение вакцины приводит к быстрому и интенсивному нарастанию в крови вакцинированных антител, обеспечивающих через 2 -3 недели невосприимчивость к инфекции в течение 1 года. НАЗНАЧЕНИЕ • Профилактика дизентерии Зонне у взрослых и детей в возрасте от трех лет.

Первоочередная вакцинация рекомендуется для : • работников инфекционных стационаров и бактериологических лабораторий; • лиц, занятых в сфере общественного питания и коммунального благоустройства; • детей, посещающих детские учреждения и отъезжающих в оздоровительные лагеря; • лиц, отъезжающих в регионы с высоким уровнем заболеваемости дизентерией Зонне. • По эпидемическим показаниям прививки проводят при угрозе возникновения эпидемии или вспышки (стихийные бедствия, крупные аварии на водопроводной и канализационной сети), а также в период эпидемии, при этом в угрожаемом районе проводят массовую иммунизацию населения. Профилактические прививки против дизентерии Зонне предпочтительно проводить перед сезонным подъемом этой инфекции. • СПОСОБ ПРИМЕНЕНИЯ И ДОЗИРОВКА • Прививки производят однократно. • Вакцину вводят глубоко подкожно или внутримышечно в наружную поверхность верхней трети плеча. Прививочная доза составляет 0, 5 мл (50 мкг) для всех возрастов. • Ревакцинацию проводят при необходимости ежегоднократно той же дозой препарата.
79adc5db_zan_n_2_enerobakterii_2015 (1).ppt